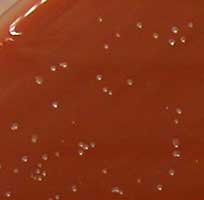

GENERALITES
Les bactéries du genre Neisseria se caractérisent par un aspect morphologique particulier: diplocoques à Gram négatif se présentant sous la forme de grains de café ou diplocoques à face aplatie, par ailleurs aérobies stricts. Plusieurs espèces commensales peuvent être isolées au sein de la flore oropharyngée de l'homme telles N. sicca, N. flava... Deux espèces sont pathogénes pour l'homme :
- N. meningitidis, agent régulièrement identifié lors de cas de méningite cérébrospinale (1 cas pour 100.000 habitants/an en France)
- N. gonorrhoeae, agent de la gonococcie, de la blennorragie ou encore de la gonorrhée. Cette maladie vénérienne peut entrainer de graves complications chez la femme.
CLASSIFICATION DES PRINCIPALES ESPECES DE LA FAMILLE DES NEISSERIACEAE RETROUVEES CHEZ L’HOMME

Deux possibilités pour les Branhamella et Moraxella

Nous n’envisagerons ici que les Neisseria, en se focalisant sur les deux espèces responsables d’infections chez l’homme : Neisseria meningitidis et Neisseria gonorrhoeae
 |
 |
PRINCIPAUX CARACTERES DES NEISSERIA
- coques à Gram négatif immobiles
- disposition en diplocoques à face aplatie ou en tétrades
- aérobies strictes (mais nécessité d’un enrichissement en CO2)
- Bactéries fragiles et sensibles aux variations de température, d’où la nécessité de milieux de culture riches tels la gélose au sang cuit ou chocolat supplémentée ou non (Polyvitex®, Supplément G).
NB : Le Supplément G contient du plasma de cheval, de l'extrait de levure, de l'extrait globulaire et du glucose. (Avantage = Transparent)
- Possibilité d'un milieu sélectif en ajoutant dans ce milieu, les antibactériens suivants : Vancomycine, 3 µg/ml; Colistine, 7,4 µg/ml et Fungizone = 2 µg/ml. Ces milieux enrichis permettent la croissance de N. meningitidis et N. gonorrhoeae mais aussi celle de N. lactamica. L'intérêt des milieux sélectifs est double, d'une part pour la primoculture en cas de prélèvements polymicrobiens, d'autre part pour l'identification ultérieure.
- Les conditions d’incubation sont strictes : 35-37°C, humidité et incubées en CO2(5-10%).
CONSERVATION
. Les Neisseria possèdent une autolysine restant active même à basse température ce qui en fait des bactéries fragiles devant être repiquées quotidiennement.
. Conservation : congélation à - 80°C en glycérol (ou par lyophilisation)
. Transport : gélose à l’ascite et au chocolat en tube de 17. Incuber 16-18 h à 37°C avant l’expédition. Recouvrir la pente de culture d’huile minérale stérile. Il existe un milieu de transport disponible auprès du Centre National de Référence des Méningocoques (Dr. J-M. Alonso, Institut Pasteur, Paris)
CARACTERES D’IDENTIFICATION RECHERCHES :
| 1. Aspect des colonies : - Taille: petites colonies pour N. gonorrhoeae et taille plus importante après 24 heures de culture pour N. meningitidis - Pigmentation: possibilité de pigmentation jaunâtre pour N. lactamica. 2. Examen microscopique - Neisseria et M. catarrhalis : diplocoques à Gram Négatif (Pas de différence morphologique entre ces deux taxons) |
 |
- Kingella - Moraxella - Acinetobacter : diplobacilles Gram -
Mais possibilité de formes coccoides pour Acinetobacter. Pour démasquer les formes bacillaires, faire un Gram à partir des bactéries prélèvées à la limite de la zone d’inhibition produite par un disque de pénicilline G.
3. Oxydase +


4. Catalase +

5. Conditions de croissance :
- Exigences très strictes du gonocoque (CO2, 37°C et suppléments nutritifs)
- N. meningitidis est moins exigeant, subculture possible sur Mueller-Hinton (milieux recommandés pour effectuer les agglutinations). Absolue nécessité de CO2 et de milieux riches pour la primoculture.
- Autres espèces : 37°C, sans CO2 et milieux nutritifs ordinaires (BHI). D'une façon générale, les milieux enrichis incubés en présence de CO2 facilitent la croissance en 24 h, surtout lors de primoculture.
- Milieu sélectif VCN pour les prélèvements polymicrobiens mais aussi pour l'identification de N. gonorrhoeae, N. meningitidis, et N. lactamica.
6. Hydrolyse de différents substrats
| - Hydrates de carbone : Recherche d'une acidification et NON D'UNE FERMENTATION (+++). Le Milieu de référence est la gélose " Cystine Tryptic Agar " + 1% glucose, maltose, fructose, saccharose, et lactose. L'indicateur de pH est le rouge de phénol. Inoculation dense de la zone d'aérobiose (eau de condensation). Ne pas bloquer les capsules des tubes à vis et ne pas incuber sans CO2. Si + , la partie haute du tube s'acidifie et change de couleur (devient jaune). En pratique, ensemencer une galerie API NH. |
 |
- Recherche d'une ß-galactosidase : Suspension dense de bactéries dans 1 ml d'eau stérile + disque d'ONPG puis incuber à 37°C. Si + , coloration jaune en 10 - 15 minutes : N. lactamica est + , N. meningitidis est -. En pratique, ensemencer une galerie API NH.
- Présence d'une gamma-glutamyl-transférase (GGT) : Réactif + öse de culture en suspension 37°C. Apparition d'une coloration jaune (lecture en 2, 3, 24h) si +. En pratique, ensemencer une galerie API NH.
+ chez N. meningitidis mais - chez N. gonorrhoeae et N. lactamica
| - Présence d'une désoxyribonucléase (DNase) : Sur gélose à l'ADN ensemencer la bactérie à étudier, 37°C, Après 24h, révêler avec le réactif de Frazier (acide chlorydrique). + chez M. catarrhalis. Très bon caractère différentiel avec les Neisseria qui en sont dépourvues. |
 |
- Hydrolyse de la tributyrine : Même valeur que la recherche de la DNAse (différence Branhamella-Neisseria) mais plus difficile à réaliser.
En pratique clinique humaine, les problèmes se résument généralement à l'identification de coques à Gram-négatif aérobies qui peuvent correspondre à N. meningitidis, N. gonorrhoeae et B. catarrhalis. En dehors de ces espèces, la réponse : "Neisseria sp" est généralement suffisante et l'identification précise sera réalisée, si besoin est, par le Centre National de Référence, en fonction du contexte clinique de l'isolement.
- Cocci à Gram - aérobie stricte
- Gélose VCN : si culture +, N. meningitidis, N. gonorrhoeae, N. lactamica (si pigmentation jaunâtre argument en faveur de N. lactamica)
- Galerie de sucres :
glucose +, maltose -, autres sucres - = N. gonorrhoeae (G+)
glucose + maltose +, autres sucres - = N. meningitidis (MG +) ou N. lactamica
GGT + : N. meningitidis ; ß-galactosidase + : N. lactamica
- Identification de M. catarrhalis : croissance VCN -; acidification des sucres - et présence d'une DNAase
En pratique, on ensemence une galerie API NH (exemple d'une souche de N. gonorrhoeae)

NEISSERIA MENINGITIDIS
I La bactérie - Typage du méningocoque : Groupage, typage et sous-typage
La capsule
- Au moins 12 sérogroupes différents (A, B, C, X, Y, Z, 29 E, W135...). Les infections sont dues aux groupes A, B, C et plus récemment W135 qui sont les sérogroupes à rechercher lors d'un isolement.
- Détermination par agglutination sur lame d'une culture de 18 h sur Mueller-Hinton,
- + si agglutination en moins de 1 min
- Faire un témoin pour détecter les souches polyagglutinables = recherche d'agglutination en 0,9% NaCl
- La capsule a un rôle essentiel dans la virulence de la bactérie en permettant la résistance à la phagocytose et à l'activité bactéricide du sérum. Toutes les souches virulentes sont capsulées.
- Les anticorps contre la capsule sont protecteurs et le polysaccharide capsulaire constitue le principe vaccinal. Pour le sérogroupe B, le polysaccharide est de même nature qu'un sucre présent au niveau du cerveau et n'est donc pas immunogène. Il n'existe donc pas de prophylaxie vaccinale contre le principal sérogroupe pathogène.
Le lipooligosaccharide (LOS)
- C'est l'endotoxine bactérienne
- Il est différent de celui des entérobactéries. En effet, il ne comporte pas de chaîne latérale mais seulement un lipide A et un core oligosaccharidique qui peut être sialylé
- On distingue différents immunotypes :
L1 à L8 retrouvés dans les sérogroupes B et C
L9 à L11 retrouvés dans le sérogroupe A
- Rôle important dans le choc septique
Protéines de membrane externe (PME)
5 classes de PME majoritaires individualisées sur la base de leur poids moléculaire
- PME de classe 1
porine.
à la base de classification en sous-types
- PME de classe 2-3 :
mutuellement exclusives
porines
à la base d'une sérotypie
- PME de classe 4 : rôle inconnu
- PME de classe 5 : rôle dans l'adhésion et l'invasion aux cellules de l'hôte.
Ainsi une souche peut être définie par un sérogroupe (capsule), sérotype (protéine de classe 2/3), sous-type (protéine de classe 1) et immunotype (lipooligosaccharide).
Multi Locus Enzyme Electrophoresis (MLEE).
Consiste à analyser la migration électrophoretique de certaines enzymes du métabolisme. Une telle approche a permis d’individualiser des électrotypes. Il s’agit d’une très bonne technique mais difficile à mettre en oeuvre et réservée à certains laboratoires. N’est plus utilisée depuis l'avènement du MLST (voir ci-dessous).
Multi Locus Sequence Typing (MLST)
- La comparaison des souches de méningocoque a récemment bénéficié de l’apport d’une nouvelle technique épidémiologique, le " Multi Locus Sequence Typing " (MLST). Cette technique est basée sur la comparaison des séquences de gènes codant pour des protéines cytoplasmiques du métabolisme fondamental (enzyme dites "de ménage", LDH par exemple) et donc non soumis à la pression de sélection de l’environnement. Ainsi, le degré d'identité entre deux séquences correspondant au même locus dans deux souches est inversement proportionnel au nombre d'évènements ayant affecté la séquence originelle pour chaque souche, et reflète donc le degré de "proximité" génomique des deux souches. Pour des détails plus importants sur cette technique voir http://www.mlst.net/. L'avantage de cette technique est sa facilité de mise en œuvre dans des laboratoires distincts.
- La caractérisation génotypique d’un nombre important de souches a permis de montrer que les méningocoques peuvent être regroupés en complexes clonaux à l’intérieur desquels les souches sont très proches. L’analyse d’isolats de patients montre que les souches isolées de patients appartiennent à un nombre très limité de complexes clonaux, alors que les souches isolées de portage appartiennent à plusieurs centaines de complexes clonaux. Ces données démontrent que les souches de N. meningitidis qui appartiennent à un petit nombre de complexes clonaux ont un potentiel invasif plus marqué que les autres. Il est cependant important de rappeler que ces souches "invasives" ne sont responsables d'infections que chez une faible proportion des patients qu'elles colonisent.
II. L’infection méningococcique - Histoire naturelle
- Neisseria meningitidis est une bactérie strictement humaine qui ne survit pas dans l’environnement. La seule niche connue est le nasopahrynx de l’homme qu'elle colonise chez environ 5 à 15 % d’une population donnée. Dans certaines circonstances favorisant la promiscuité, ce taux de colonisation peut atteindre 40 % (casernes, grands rassemblements ...). Ce n’est que chez une très faible fraction des sujets colonisés que la bactérie va disséminer à partir du nasopharynx et envahir le sang circulant. Une fois dans le sang, la bactérie pourra être responsable :
| - Soit d’un purpura fulminans (1/3 des infections méningococciques) qui est le fruit d’une multiplication intensive de la bactérie dans le sang et qui est responsable d’un choc septique surprenant par la rapidité de son développement et sa sévérité et ceci compte tenu du terrain sous-jacent habituellement sain. Le purpura fulminans reste mortel dans 30% des cas. Le pronostic est fonction de la précocité d’administration d’un antibiotique (voir recommandations du Conseil Supérieur d’Hygiène). |
 |
- Le plus souvent (2/3 des cas), la phase sanguine passera inaperçue et la bactérie franchira la barrière hémato-encéphalique pour donner une méningite qui a un pronostic favorable lorsqu’elle est correctement traitée puisque la mortalité est faible (2 à 4 %)
- Exceptionnellement un tableau chronique s’installe, lié à de faibles bactériémies difficiles à diagnostiquer.
IMPORTANT
- L’infection méningococcique peut être considérée comme un accident au cours d’un portage. En effet, l’infection ne confère pas d'avantage sélectif à la bactérie puisqu’elle aboutit à la mort de son hôte sans favoriser sa dissémination. N. meningitidis ne doit donc pas être considéré comme un pathogène mais comme un COMMENSAL du nasopharynx de l’homme.
- Pourquoi cet accident ? Trois hypothèses non exclusives sont avancées :
- L'environnement favorise la survenue de l'infection, une infection virale récente par exemple. Le pic d'infections méningocociques est précédé de quelques jours par un pic d'infections grippales.
- L'hôte : certains sujets sont génétiquement prédisposés à faire une infection. Les déficits en fraction terminale du complément en sont un bon exemple.
- La souche : les données épidémiologiques obtenues grâce au MLST ont très clairement démontré que les souches invasives appartiennent à un petit nombre de complexes clonaux, ce qui suggère que ces souches ont des facteurs de virulence qui leur sont spécifiques. Mais la maladie reste une conséquence rare de la colonisation, même pour une souche "invasive".
III. N. meningitidis - Facteurs de virulence
- Neisseria meningitidis est un pathogène à multiplication extra-cellulaire.
- Les facteurs qui permettent sa dissémination à partir du nasopahrynx sont inconnus.
- Une fois dans le sang circulant, les principaux facteurs de virulence actuellement identifiés sont :
- La capsule polysaccharidique et la sialylation du LOS qui permettent de résister à l'action bactéricide du sérum et à la phagocytose par les polynucléaires ;
- les systèmes de captation du fer (récepteurs sur la membrane externe pour la transferrine et les dérivés de l'hémoglobine)
- la bactérie a la capacité de franchir la barrière hémato-encéphalique au niveau des plexus choroides et/ou des capillaires méningés après internalisation et transcytose au travers des couches cellulaires. Le principal facteur de virulence à ce niveau sont les pili de type IV qui permettent à la bactérie d'adhérer aux cellules endothéliales. Le principal facteur actuellement identifié comme jouant un rôle dans la transcytose est l'IgA protéase.




- Bon nombre d'inconnues persistent quant à la virulence de N. meningitidis, notamment pour ce qui est spécifique aux souches des complexes clonaux invasifs. Le génome de plusieurs souches est actuellement connu et accessible sur http://www.tigr.org/tigr-scripts/CMR2/CMRGenomes.spl. Les comparaisons génomiques entre souches virulentes et non virulentes devraient permettre l'identification des facteurs spécifiques des souches invasives.
IV. L’infection méningococcique - Epidémiologie

En fait 2 types d’épidémiologies :
- Endémo-épidémique (Europe, Amérique du Nord), prédominance des sérogroupes B et C. En France :
- 1 cas /100.000 habitants/an environ, variable d'une année sur l'autre
- 8.5 cas/100.000 si l'enfant est adolescent
- Prédominance des sérogroupes B (60%) et C (30%), A (3%)
- Epidémique (Afrique entre les deux tropiques = ceinture méningée). Prédominance du sérogroupe A et plus récemment apparition de W135
Pour des données épidémiologiques plus précises et actualisées voir les sites institutionnels :
http://www.sante.gouv.fr/htm/pointsur/infections/index.htm
http://neisseria.org/
http://www.cdc.gov/ncidod/dbmd/diseaseinfo/meningococcal_g.htm
V. Diagnostic de l’infection méningococcique
Le diagnostic direct repose sur l'isolement de la bactérie ou certains de ses facteurs
- Les prélèvements à partir desquels la bactérie est isolée sont
- LCR
- Hémoculture
- Lésions cutanées
- Liquide pleural, péricardique articulaire
- Prélèvement de gorge
- La présence d'antigènes solubles (LCR, urines)
- La recherche d'ADN bactérien par amplification génique dans le LCR et le sérum (CNR, Dr J-M Alonso, Institut Pasteur, Paris)
Une circulaire de la DGS/SD5C/2002/400 du 15 juillet 20002 précise la définition des cas d'infections méningococciques invasives (http://www.sante.gouv.fr).
Conformément à l’avis du CSHPF du 16 mai 2002 (annexe 4), est considéré comme cas d’infection invasive à méningocoque, tout cas remplissant l’une au moins des conditions suivantes :
1/ Isolement bactériologique de méningocoques à partir d'un site normalement stérile (sang, L.C.R., liquide articulaire, liquide pleural, liquide péricardique) OU à partir d'une lésion cutanée purpurique.


2/ Présence de diplocoques Gram négatif à l'examen direct du L.C.R.


3/ L.C.R. évocateur de méningite bactérienne purulente (à l'exclusion de l'isolement d'une autre bactérie) ET :
- Soit, présence d'éléments purpuriques cutanés quel que soit leur type.
- Soit, présence d'antigène soluble méningococcique dans le L.C.R., le sang ou les urines.
- Soit, PCR positive à partir du LCR ou du sérum.
|
4/ Présence d'un purpura fulminans (purpura dont les éléments s'étendent rapidement en taille et en nombre, avec au moins un élément nécrotique ou ecchymotique de plus de trois millimètres de diamètre associé à un syndrome infectieux sévère, non attribué à une autre étiologie).
|
 |
VI. L’infection méningococcique - Traitement anti-infectieux
VI.1 Sensibilité aux antibiotiques
Effectuer l'antibiogramme, de préférence, sur le milieu de Mueller-Hinton normal
Résistance aux antibiotiques : Bactérie généralement sensible à la plupart des antibiotiques mais :
- souches de sensibilité diminuée aux pénicillines (ß-lactamines) (CA-SFM: 0,06 < CMI < 1 mg/l).
- résistance acquise au chloramphénicol (CA-SFM: 2 < CMI < 4 mg/l, D < 30 mm).
- résistance acquise à la rifampicine (CA-SFM: CMI < 0,25 mg/l, D < 30 mm).
http://www.sfm.asso.fr/
Résistance aux ß-lactamines :
- Quelques cas exceptionnels par production de ß-lactamase :
|
Identifiée pour 4 souches (1 Canada, 2 Espagne, 1 Afrique du Sud, ) Enzyme de type TEM-1 d’origine plasmidique Détection chromogénique à l'aide d'un disque de nitrocéfine |

- Plus fréquemment, une sensibilité altérée par diminution d’affinité des PLP : Grande hétérogénéité génotypique, transfert horizontal de gènes modifiés. Ex : modification de penA chromosomique par formation de mosaïque à partir de souches de Neisseria non pathogènes moins sensibles (N. flavescens, N. cinerea).
| . Pénicilline G : (CA-SFM: 0,125 < CMI < 1 mg/l). . Parfois associée à une diminution de la perméabilité de la membrane externe. Les C3G conservent une excellente activité (céfotaxime, CTX) . 18% des souches adressées au CNR en 1996 . Dépistage parfois peu aisé, par emploi d’un disque d’oxacilline (1 ou 5 µg) ou par E-test. |
Résistance aux Sulfamides :
- Utilisés depuis les années 30
- Résistance décrite en 1963 par modification de l'enzyme DHPS
- 50% des souches du CNRM en 1996
- Ne pas employer a priori de milieu au sang cuit : recherche parfois faussement positive par la présence de thymidine dans le milieu
Résistance au Chloramphénicol :
- Résistance exceptionnelle (CMI > 64mg/l), initialement décrite au Vietnam
- Production de Chloramphénicol-Acyl-Transférase (CAT)
Résistance à la Rifampicine :
- Parfois associée à une diminution de la perméabilité de la membrane externe
- Rare (0,02% au CNRM en 1996) mais franche (100 fois la CMI d’une souche sauvage)
Résistance à la Spiramycine :
- Produit de réserve en prophylaxie, liaison au ribosome
- 0,8% de souches résistantes au CNR en 1995
- L'incubation sous CO2 conduit à surestimer les résistances aux macrolides.
VI.2 Traitement
Le traitement antibiotique repose généralement sur l’administration de céphalosporines de 3ème génération (céfotaxime, ceftriaxone). En cas de purpura fulminans, le pronostic dépend de la précocité du traitement antibiotique, la circulaire de la DGS/SD5C/2002/400 du 15 juillet 2002 souligne la nécessité de faire une injection d 'antibiotique devant tout malade présentant un purpura suspect, et ceci avant tout prélèvement et transfert en milieu hospitalier : http://www.sante.gouv.fr/htm/pointsur/infections/index.htm
Le malade doit être transféré d’urgence à l’hôpital. L’intervention d’une équipe médicalisée expérimentée (SMUR) est justifiée sous réserve que son délai d’intervention soit inférieur à 20 minutes. Dans tous les cas, les urgences de l’hôpital doivent être alertées de l’arrivée d’un cas suspect de purpura fulminans, afin que son accueil puisse être préparé.
| Conformément à l'avis du CSHPF du 10 mars 2000 (cf. annexe 1), en dehors du milieu hospitalier, tout malade présentant des signes infectieux et à l'examen clinique, lorsqu'il a été totalement dénudé, un purpura comportant au moins un élément nécrotique ou ecchymotique de diamètre supérieur ou égal à 3 millimètres, doit immédiatement recevoir une première dose d'un traitement antibiotique approprié aux infections à méningocoques, administrée si possible par voie intraveineuse, sinon par voie intramusculaire, et quel que soit l'état hémodynamique du patient. |
VI.3 Chimioprophylaxie
- Une chimioprophylaxie doit être instituée dans l’entourage d’un patient présentant une infection invasive à méningocoque comme définie ci-dessus. Cette chimioprophylaxie concerne les sujets susceptibles d'être contaminés par la même souche que le patient, à savoir les sujets contacts. La circulaire(http://www.sante.gouv.fr/htm/pointsur/infections/index.htm) donne une définition précise des sujets contacts. Très globalement, il s'agit de sujets ayant des contacts rapprochés et répétées avec le cas index (vivant sous le même toit par exemple). Voir Tableau sujets contacts.pdf
- Principe de la prophylaxie: prévention des cas secondaires
Objectifs :
- Empêcher l’acquisition de la bactérie et/ou l’infection chez les sujets " contact " d’un cas.
- Rompre la chaîne de transmission d’une souche virulente en empêchant sa diffusion secondaire à une population sensible par des porteurs sains.
Remarque : le risque d'exposition du personnel de laboratoire au méningocoque, pathogène de classe 2, reste limité au cas de souillure des muqueuses oculaires, nasales ou buccales.
- La chimioprophylaxie doit être réalisée dans les plus brefs délais, autant que possible dans les 24 à 48 heures suivant le diagnostic de cas d'infection invasive à méningocoque, et n'a plus d'intérêt au-delà d'un délai de 10 jours après le dernier contact avec le cas, compte tenu du délai d'incubation. Ceci impose que le cas soit signalé immédiatement au médecin de la DDASS.
- L'antibiotique administré autour d'un malade doit être efficace sur Neisseria meningitidis et ne doit pas sélectionner de souches résistantes. Il doit atteindre des concentrations salivaires supérieures à la concentration minimale inhibitrice (CMI) pour Neisseria meningitidis. Son action doit être rapide et prolongée dans le temps. Il ne doit pas décapiter une éventuelle infection invasive. Il doit être bien toléré et avec peu de contre-indications. Il doit être d'un emploi pratique avec un traitement de courte durée. Le médicament qui répond le mieux à ces critères est la rifampicine qui réduit le portage avec un succès de 75 à 98 % une semaine après le traitement, le taux de réacquisition étant faible, d'environ 10 % au bout d'un mois. Depuis plus de 10 ans on peut constater que cette antibioprophylaxie est efficace puisque les cas secondaires ont été inférieurs à 2 %. Il est important de ne pas faire une utilisation abusive de la rifampicine en prophylaxie compte tenu de son rôle primordial dans le traitement de la tuberculose. En cas de contre-indication à la rifampicine, la spiramycine est recommandée. Elle a des taux salivaires élevés, elle nécessite un traitement de 5 jours pour obtenir une efficacité de 85 %. D'autres antibiotiques sont à l'étude, mais en l'état actuel des données, la rifampicine reste le traitement recommandé.
- Schéma de la chimioprophylaxie
* Rifampicine par voie orale, pendant 2 jours à la dose suivante :
| Adulte : 600 mg, 2 fois par jour, Nourrisson et enfant (1 mois à 15 ans) : 10 mg/kg, 2 fois par jour, Nouveau-né (moins de 1 mois) : 5 mg/kg, 2 fois par jour. Ce médicament ne doit jamais être utilisé dans les cas suivants : hypersensibilité à l'un de ses composants et aux rifamycines, porphyries, associations avec des médicaments (delavirdine) et association avec les antiprotéases. Ce médicament ne doit généralement pas être utilisé en association avec les contraceptifs oestroprogestatifs et progestatifs, et la nevirapine. Il est important de prévenir toute jeune fille ou femme en âge de procréer de la diminution de l'efficacité des contraceptifs oraux en cas de prise de se médicament et de la nécessité d'utiliser une contraception de type mécanique. La rifampicine modifie la pharmacocinétique de nombreux médicaments. Effets secondaires : la rifampicine peut entraîner une coloration rouge des sécrétions et colorer de façon permanente des lentilles de contacts souples. Grossesse : l'utilisation de la rifampicine ne doit être envisagée au cours de la grossesse qu'en l'absence d'alternative thérapeutique. + En cas de contre-indication à la rifampicine : |
* Spiramycine par voie orale, pendant 5 jours à la dose suivante :
| Adulte : 3 millions d'U.I., 2 fois par jour, Nourrisson et enfant : 75 000 U.I./kg, 2 fois par jour. Contre-indications : allergie à la spiramycine. NB : Dans la mesure où le résumé des caractéristiques du produit est susceptible d'évoluer, il appartient au médecin prescripteur de s'assurer du respect des caractéristiques du produit en vigueur au moment de la prescription. |
- Isolement septique : En principe, selon la Société Française d’Hygiène Hospitalière (1998) :
Isolement en chambre individuelle ou regroupement les patients atteints
Port de masque pour le personnel soignant
MAIS, selon l’OMS : La majorité des cas de transmission a pour origine les porteurs sains et non les malades
La contagiosité baisse rapidement lors du traitement
Germe fragile
Et donc pas d’isolement nécessaire …
- Mesures inefficaces et inutiles : Certaines mesures sont inefficaces et inutiles; elles sont donc à proscrire. Ceux sont :
La désinfection rhino-pharyngée et le prélèvement rhino-pharyngé ;
L'éviction de la collectivité et en particulier l'éviction scolaire des frères et soeurs ;
L'isolement des sujets contacts ;
La désinfection ou la fermeture d'un établissement (scolaire par exemple) vu la fragilité du méningocoque.
VI.4 Vaccination


Une vaccination est possible pour la prévention des infections à méningocoque de sérogroupe A, C, Y et W135. Le principe vaccinal est constitué de polysaccharide capsulaire purifié. Une injection protège 3 ans et l’immunité apparait 10 jours après l’injection. Comme tous les vaccins polysaccharidiques, ces vaccins sont très peu efficaces chez le nourisson et n’induisent pas de réponse mémoire. Récemment un vaccin conjugué a fait son apparition pour le sérogroupe C. Il est efficace dès l’âge de 2 mois.
Indications de la vaccination :
- Le vaccin polysaccharidique méningococcique A + C est obligatoire en France chez les militaires depuis septembre 1992.
- En cas de contage avec un patient présentant une infection méningococcique A ou C, il est recommandé de vacciner, une fois le sérogroupe connu, les sujets contacts appartenant à l’entourage proche du malade et les sujets contacts qui se retrouvent régulièrement et de façon répétée dans la collectivité fréquentée par le malade.
- Pour les voyageurs, le vaccin est recommandé en cas de résidence ou de randonnées dans les zones à risques (ceinture méningée en Afrique). L' Arabie Saoudite exige depuis 1988 la vaccination pour les pèlerins se rendant à la Mecque. Le vaccin tétravalent est recommandé pour les pèlerins se rendant à la Mecque et ceci en raison d’un important contage par des souches de sérogroupe W135 durant cette période. Seul le vaccin A + C est disponible en France mais sous certaines conditions un vaccin tétravalent peut être disponible. (http://www.sante.gouv.fr/htm/pointsur/infections/index.htm)
- Enfin les autorités sanitaires peuvent décider d’une campagne de vaccination dans des zones délimitées où l’incidence du méningocoque de sérogroupe C est particulièrement élevée (cas groupés ou épidémie).
NEISSERIA GONORRHOEAE
I. La bactérie
Neisseria gonorrhoeae est une bactérie très proche de N. meningitidis dont la population est beaucoup plus homogène que pour ce dernier. N. gonorrhoeae doit être considéré comme un "sous-type" de N. meningitidis qui s'est adapté à une niche différente puisque son site de prédilection est l’appareil urogénital féminin. Il n’y a pas de technique de typage pratiquée en routine.
Le génome d’une souche de N. gonorrhoeae a été séquencé et les comparaisons de génome montrent que 80 à 90% des phases de lecture présentes chez N. meningitidis sont retrouvées chez N. gonorrhoeae. La plupart des protéines et composants identifiés chez N. meningitidis existent donc aussi chez N. gonorrhoeae. Une différence majeure est l'absence de capsule polysaccharidique chez N. gonorrhoeae.
II. L'infection gonococcique - Histoire naturelle
Comme pour N. meningitidis, le seul hôte connu pour N. gonorrhoeae est l'homme, et la bactérie ne survit pas dans l'environnement. La niche est cependant différente puisqu'il s'agit de l'appareil urogénital de la femme où la bactérie est le plus souvent asymptomatique. En revanche chez l'homme, l'infection s'accompagne d'une intense inflammation responsable de l'uréthrite. La dissémination est exclusivement par voie sexuelle.
Il existe d'exceptionnelles souches responsables d'infections invasives.
Problème de santé publique
III. L’infection gonococcique - Diagnostic
Le diagnostic repose exclusivement sur l'identification de la bactérie.
- Les prélèvements à partir desquels la bactérie est isolée sont :
- prélèvement de l'endocol
- prélèvement uréthral
- prélèvement rectal
- prélèvement pharyngé
- prélèvement oculaire
- prélèvement cutanée
- liquide articulaire (formes invasives)
- hémoculture (formes invasives)
- Examen direct - Culture
. Examen direct : La présence de bactéries est recherchée soit par coloration de bleu de méthylène (en particulier lors du diagnostic bactérioscopique au CDAG), soit après coloration de Gram. L' élément pathonomonique est l'observation de germes intracellulaires au sein de polynucléaires.


A la coloration de Gram, il s'agit de diplocoques à Gram négatif en forme de grain de café, le plus souvent associé à de nombreux polynucléaires dans les formes aigues.
. La culture est indispensable sur des milieux riches et sélectifs (vancomycine par exemple). Le délai de croissance est en moyenne de 2 à 4 jours d'incubation à 37°C et en présence de 5 à 10% de gaz carbonique.
Exemple de culture sur le milieu sélectif VCN après 48 h d'incubation à 37°C et en présence de CO2
. L'identification de cette espèce est biochimique après 24 h d'incubation à 37°C (galerie API NH).

Il n'y a pas de diagnostic indirect (sérologie).
IV. L’infection gonococcique - Traitement anti-infectieux
| Résistance naturelle : Triméthoprime - Lincosamides - Colistine - Vancomycine, d'où l'existence de milieux sélectifs. Mais de rares souches sont "hypersensibles" à la lincomycine, l’érythromycine, la rifampicine, ou à la vancomycine (10%), d’où la nécessité d'employer également des milieux non sélectifs. Résistances acquises : apparues depuis longtemps, donc ne pas oublier d'effectuer un antibiogramme sur le milieu de Mueller-Hinton enrichi au sang. Exemple d 'une souche de gonocoque multirésistante (les symboles des disques sont indiquées dans le texte) http://www.sfm.asso.fr/ |
 |
ß- lactamines (CA-SFM pénicilline G : 0,06 < CMI < 1mg/l):
CMI < 0,06 mg/l jusqu’en 1960, Résistance si CMI > 1mg/l. Exemple de résistance à l’amoxicilline(AMX).
Echecs thérapeutiques à la pénicilline G à partir de 1980 :
Résistances chromosomiques : Mutations additives de gènes chromosomiques (penAB, mtrRCDE, ampABCD) (CMI parfois < 16mg/l), parfois couplées. Inhibiteurs de pénicillinase inefficaces.
Pénicillinase plasmidique décrite depuis 1976, inhibiteurs de pénicillinase généralement efficaces. Observer la synergie entre AMX et AMC. La détection chromogénique (céfinase) est meilleure (cf méningocoque)
. Pour les céphalosporines, les pénicillinases sont peu actives mais les mutations chromosomiques élèvent beaucoup les CMI, qui restent cependant souvent sous le seuil de résistance. C1G peu actives, C2G (céfuroxime) généralement actives, C3G peu touchées par les pénicillinases, plus par les résistances chromosomiques (CMI x 4 à 8) mais les CMI des souches sensibles sont très basses, donc activité généralement conservée.
- Ceftriaxone plus active que Céfotaxime.
- Imipénème: stable aux Pénicillinases mais faiblement affecté lors de résistance chromosomique.
- Souvent en pratique : plusieurs résistances associées.
- Fréquence : 5 à 10% en Europe et aux USA
- 30 à 65% en Asie ou en Afrique.
Tétracyclines (TE) (CA-SFM: c < 1 et C > 4 mg/l, d < 19 mm):
Activité comparable entre la doxycycline et la minocycline
Echec thérapeutique si CMI > 2mg/l
Non conseillé dans le traitement du gonocoque (R fréquentes) mais actives sur les Chlamydiae souvent associées.
Résistance chromosomique souvent liée à celle déjà évoquée pour les pénicillines (les loci penB et tet sont proches).
- 30% en Europe
- 70% en Asie du Sud Est
- Résistance plasmidique : CMI >16mg/l par insertion plasmidique de tetM. La détection est habituellement simple (cf antibiogramme)
- 20% en Amérique du Nord
- Fréquente en France
Aminoglycosides
| - La Spectinomycine (SPT) est exclusivement réservée au traitement de la gonococcie (CA-SFM: c < 64, C > 64 mg/l, d < 20, D > 20 mm): - Résistance par altération de la sous-unité 30S du ribosome - 10% dans le Sud Est asiatique, souvent associé à d’autres résistances |
 |
Fluoroquinolones
- Ciprofloxacine et Ofloxacine sont les plus actives.
- Résistance croisée entre fluoroquinolones par mutation de gyrA et parC
- Rare en Europe mais fréquent au Japon et en Asie du SE (20%)
- Ne pas oublier de tester une quinolone classique comme l'acide nalidixique (NA)(cf antibiogramme: D > 25 mm) au lieu d'une fluoroquinolone telle péfloxacine (PEF) et ciprofloxacine (CIP)(CIP: c < 0,06 et C > 0,06 mg/l; OFX: c < 0,12 et C > 12 mg/l).


En cas de doute, effectuer une détermination de CMI avec le E-test (exemple de la ciprofloxacine ou CI)

EN PRATIQUE (Pilly 1996)
Urétrite et cervico-vaginite : dose unique
- 400 mg Céfixime (OROKEN®) po
- 2 g spectinomycine IM (TROBICINE®)
- 800 mg péfloxacine (PEFLACINE®) po
- 400 mg ofloxacine (OFLOCET®) po
- 250 mg ciprofloxacine (CIFLOX®) po
- 250 mg ceftriaxone IM (ROCEPHINE®), hors AMM
- Traitement prolongé si localisation anale ou pharyngée
Salpingites (C. trachomatis aussi impliqué) : TTT per os ou IV :
- AUGMENTIN® (3-6g/j 5j puis 2-3g/j 8j)+ Cycline (200 mg/j 3sem)
- En seconde intention :
- Augmentin® + Ofloxacine
- C2G ou C3G + métrodinazole + cycline
- Clindamycine + gentamicine
- Clindamycine + doxycycline
Portage durant la grossesse : amoxicilline (2g/j 7j) si Sensible. sinon, Augmentin® ou C3G
Ne pas oublier l'éventuel traitement simultané du(des) partenaire(s)
Ce cours a été préparé par le Dr. P. MORAND et le Professeur X. NASSIF (Faculté de Médecine Necker-Enfants Malades, PARIS V)
Quelques adresses :
http://neisseria.org/nm
http://www.ands.dz/sap/infections-invasives2.htm
http://www.sante.gouv.fr/htm/pointsur/infections/index.htm
http://www.invs.sante.fr/beh
http://www.sfm.asso.fr
http://www.lemonde.fr/article/0,5987,3244--291133-,00.html
|
|
|
|
|